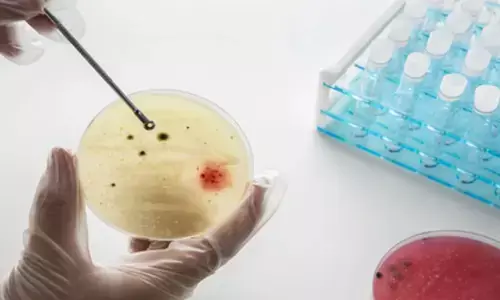
घनी आबादी वाले शहरों में फेफड़े और आंत में संक्रमण का खतरा ज्यादा : स्टडी

Begin typing your search above and press return to search.

इसरो के चंद्रयान-2 ने चंद्रमा के वायुमंडल पर सौर प्रभाव का पता लगाया
बेंगलुरु। भारत के चंद्रयान-2 मिशन ने एक वैज्ञानिक रहस्य उजागर करते हुए दुनियाभर के अंतरिक्ष वैज्ञानिकों को हैरान कर दिया है। भारतीय अंतरिक्ष अनुसंधान...